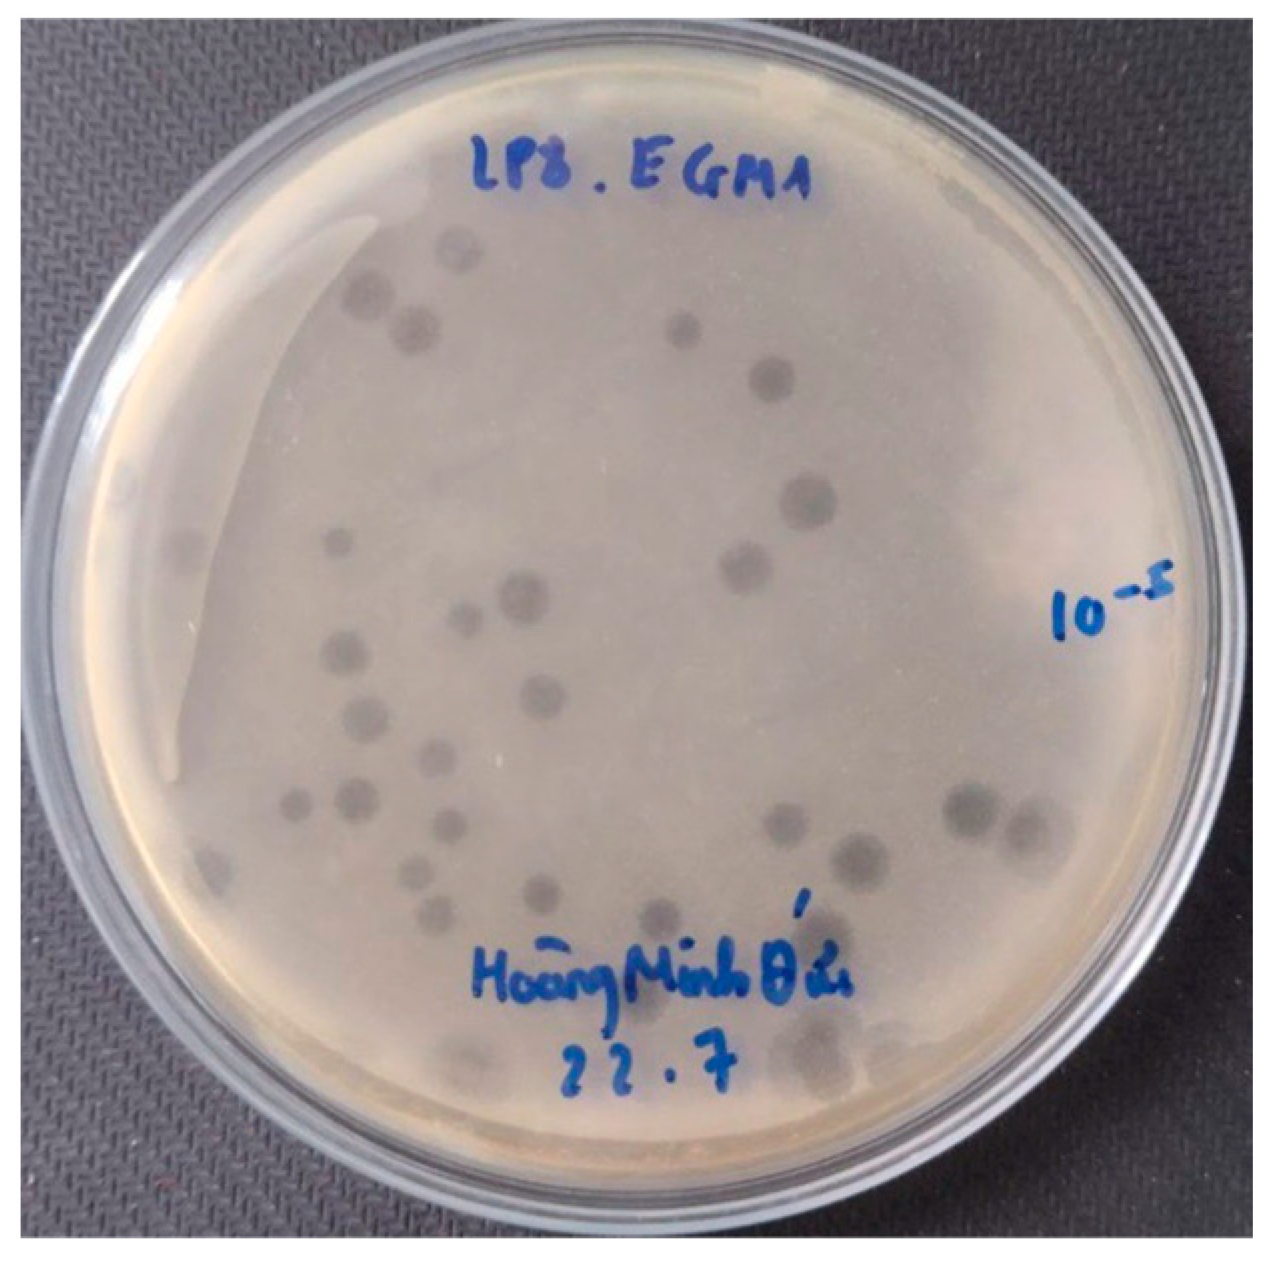
Pathogens 13 00494 g001

Antibiotic Resistance Profile and Bio-Control of Multidrug-Resistant Escherichia coli Isolated from Raw Milk in Vietnam Using Bacteriophages
Abstract
1. Introduction
2. Materials and Methods
2.1. Isolation and Identification of E. coli
2.2. Antibiotic Susceptibility Test
2.3. Detection of STEC Virulence-Associated Genes, ESBLs Encoding Genes, and mcr Genes
2.4. Phage Isolation, Purification, and Propagation
2.5. Phage Characterization
2.6. Efficacy of Phage PEM3 against EM148 in LB Broth and Raw Milk
3. Results
3.1. Prevalence of E. coli in Raw Milk
3.2. Antimicrobial Susceptibility Profile
3.3. Detection of STEC Virulence-Associated Genes, ESBL Phenotype, β-Lactamase Encoding Genes, and mcr Genes
3.4. Phage Isolation and Characterization
3.5. Efficacy of Phage PEM3 against EM148 in LB Broth and Raw Milk
4. Discussion
5. Conclusions
Author Contributions
Funding
Institutional Review Board Statement
Informed Consent Statement
Data Availability Statement
Acknowledgments
Conflicts of Interest
References
- Havelaar, A.H.; Kirk, M.D.; Torgerson, P.R.; Gibb, H.J.; Hald, T.; Lake, R.J.; Praet, N.; Bellinger, D.C.; De Silva, N.R.; Gargouri, N. World Health Organization Global Estimates and Regional Comparisons of the Burden of Foodborne Disease in 2010. PLoS Med. 2015, 12, e1001923. [Google Scholar] [CrossRef] [PubMed]
- Abebe, E.; Gugsa, G.; Ahmed, M. Review on Major Food-Borne Zoonotic Bacterial Pathogens. J. Trop. Med. 2020, 2020, 4674235. [Google Scholar] [CrossRef] [PubMed]
- Kaper, J.B.; Nataro, J.P.; Mobley, H.L.T. Pathogenic Escherichia coli. Nat. Rev. Microbiol. 2004, 2, 123–140. [Google Scholar] [CrossRef] [PubMed]
- Minh, S.H.; Kimura, E.; Minh, D.H.; Honjoh, K.; Miyamoto, T. Virulence characteristics of Shiga toxin-producing Escherichia coli from raw meats and clinical samples. Microbiol. Immunol. 2015, 59, 114–122. [Google Scholar] [CrossRef] [PubMed]
- Burow, E.; Rostalski, A.; Harlizius, J.; Gangl, A.; Simoneit, C.; Grobbel, M.; Kollas, C.; Tenhagen, B.-A.; Käsbohrer, A. Antibiotic resistance in Escherichia coli from pigs from birth to slaughter and its association with antibiotic treatment. Prev. Vet. Med. 2019, 165, 52–62. [Google Scholar] [CrossRef]
- Mcewen, S.A.; Fedorka-Cray, P.J. Antimicrobial Use and Resistance in Animals. Clin. Infect. Dis. 2002, 34 (Suppl. S3), S93–S106. [Google Scholar] [CrossRef] [PubMed]
- Anjum, M.F.; Schmitt, H.; Börjesson, S.; Berendonk, T.U.; Donner, E.; Stehling, E.G.; Boerlin, P.; Topp, E.; Jardine, C.; Li, X.; et al. The potential of using E. coli as an indicator for the surveillance of antimicrobial resistance (AMR) in the environment. Curr. Opin. Microbiol. 2021, 64, 152–158. [Google Scholar] [CrossRef] [PubMed]
- Saliu, E.M.; Vahjen, W.; Zentek, J. Types and prevalence of extended-spectrum beta-lactamase producing Enterobacteriaceae in poultry. Anim. Health Res. Rev. 2017, 18, 46–57. [Google Scholar] [CrossRef] [PubMed]
- Liu, G.; Ali, T.; Gao, J.; Rahman, S.U.; Yu, D.; Barkema, H.W.; Huo, W.; Xu, S.; Shi, Y.; Kastelic, J.P.; et al. Co-Occurrence of Plasmid-Mediated Colistin Resistance (mcr-1) and Extended-Spectrum ß-Lactamase Encoding Genes in Escherichia coli from Bovine Mastitic Milk in China. Microb. Drug Resist. 2020, 26, 685–696. [Google Scholar] [CrossRef]
- EFSA. Scientific Opinion on the public health risks related to the consumption of raw drinking milk. EFSA J. 2015, 13, 3940. [Google Scholar] [CrossRef]
- Oliver, S.P.; Boor, K.J.; Murphy, S.C.; Murinda, S.E. Food safety hazards associated with consumption of raw milk. Foodborne Pathog. Dis. 2009, 6, 793–806. [Google Scholar] [CrossRef] [PubMed]
- Potter, M.E.; Kaufmann, A.F.; Blake, P.A.; Feldman, R.A. Unpasteurized Milk: The Hazards of a Health Fetish. JAMA J. Am. Med. Assoc. 1984, 252, 2048–2052. [Google Scholar] [CrossRef]
- Jay-Russell, M.T. Raw (unpasteurized) milk: Are health-conscious consumers making an unhealthy choice? Clin. Infect. Dis. 2010, 51, 1418–1419. [Google Scholar] [CrossRef] [PubMed]
- Liu, J.; Zhu, Y.; Jay-Russell, M.; Lemay, D.G.; Mills, D.A. Reservoirs of antimicrobial resistance genes in retail raw milk. Microbiome 2020, 8, 99. [Google Scholar] [CrossRef] [PubMed]
- Eldesoukey, I.E.; Elmonir, W.; Alouffi, A.; Beleta, E.I.M.; Kelany, M.A.; Elnahriry, S.S.; Alghonaim, M.I.; Alzeyadi, Z.A.; Elaadli, H. Multidrug-Resistant Enteropathogenic Escherichia coli Isolated from Diarrhoeic Calves, Milk, and Workers in Dairy Farms: A Potential Public Health Risk. Antibiotics 2022, 11, 999. [Google Scholar] [CrossRef] [PubMed]
- Lucey, J.A. Raw milk consumption: Risks and benefits. Nutr. Today 2015, 50, 189. [Google Scholar] [CrossRef] [PubMed]
- Duc, H.M.; Son, H.M.; Ngan, P.H.; Sato, J.; Masuda, Y.; Honjoh, K.-I.; Miyamoto, T. Isolation and application of bacteriophages alone or in combination with nisin against planktonic and biofilm cells of Staphylococcus aureus. Appl. Microbiol. Biotechnol. 2020, 104, 5145–5158. [Google Scholar] [CrossRef] [PubMed]
- Mills, S.; Ross, R.P.; Hill, C. Bacteriocins and bacteriophage; a narrow-minded approach to food and gut microbiology. FEMS Microbiol. Rev. 2017, 41, S129–S153. [Google Scholar] [CrossRef]
- Moye, Z.D.; Woolston, J.; Sulakvelidze, A. Bacteriophage Applications for Food Production and Processing. Viruses 2018, 10, 205. [Google Scholar] [CrossRef]
- Tagliaferri, T.L.; Jansen, M.; Horz, H.P. Fighting Pathogenic Bacteria on Two Fronts: Phages and Antibiotics as Combined Strategy. Front. Cell. Infect. Microbiol. 2018, 10, 205. [Google Scholar] [CrossRef]
- Loc-Carrillo, C.; Abedon, S.T. Pros and cons of phage therapy. Bacteriophage 2011, 1, 111–114. [Google Scholar] [CrossRef] [PubMed]
- Duc, H.M.; Son, H.M.; Yi, H.P.S.; Sato, J.; Ngan, P.H.; Masuda, Y.; Honjoh, K.-I.; Miyamoto, T. Isolation, characterization and application of a polyvalent phage capable of controlling Salmonella and Escherichia coli O157:H7 in different food matrices. Food Res. Int. 2020, 131, 108977. [Google Scholar] [CrossRef] [PubMed]
- Minh, D.H.; Minh, S.H.; Honjoh, K.I.; Miyamoto, T. Isolation and bio-control of Extended Spectrum Beta-Lactamase (ESBL)-producing Escherichia coli contamination in raw chicken meat by using lytic bacteriophages. LWT 2016, 71, 339–346. [Google Scholar] [CrossRef]
- Golkar, Z.; Bagasra, O.; Pace, D.G. Bacteriophage therapy: A potential solution for the antibiotic resistance crisis. J. Infect. Dev. Ctries. 2014, 8, 129–136. [Google Scholar] [CrossRef] [PubMed]
- Hong, Y.; Schmidt, K.; Marks, D.; Hatter, S.; Marshall, A.; Albino, L.; Ebner, P. Treatment of Salmonella-Contaminated Eggs and Pork with a Broad-Spectrum, Single Bacteriophage: Assessment of Efficacy and Resistance Development. Foodborne Pathog. Dis. 2016, 13, 679–688. [Google Scholar] [CrossRef] [PubMed]
- Huang, H.-H.; Furuta, M.; Nasu, T.; Hirono, M.; Pruet, J.; Duc, H.M.; Zhang, Y.; Masuda, Y.; Honjoh, K.-I.; Miyamoto, T. Inhibition of phage-resistant bacterial pathogen re-growth with the combined use of bacteriophages and EDTA. Food Microbiol. 2021, 100, 103853. [Google Scholar] [CrossRef] [PubMed]
- Younis, W.; Hassan, S.; Mohamed, H.M.A. Molecular characterization of Escherichia coli isolated from milk samples with regard to virulence factors and antibiotic resistance. Vet. World 2021, 14, 2410–2418. [Google Scholar] [CrossRef] [PubMed]
- Ombarak, R.A.; Hinenoya, A.; Elbagory, A.R.M.; Yamasaki, S. Prevalence and Molecular Characterization of Antimicrobial Resistance in Escherichia coli Isolated from Raw Milk and Raw Milk Cheese in Egypt. J. Food Prot. 2018, 81, 226–232. [Google Scholar] [CrossRef] [PubMed]
- Liu, H.; Meng, L.; Dong, L.; Zhang, Y.; Wang, J.; Zheng, N. Prevalence, Antimicrobial Susceptibility, and Molecular Characterization of Escherichia coli Isolated From Raw Milk in Dairy Herds in Northern China. Front. Microbiol. 2021, 12, 730656. [Google Scholar] [CrossRef]
- Ngaywa, C.; Aboge, G.O.; Obiero, G.; Omwenga, I.; Ngwili, N.; Wamwere, G.; Wainaina, M.; Bett, B. Antimicrobial resistant Escherichia coli isolates detected in raw milk of livestock in pastoral areas of northern Kenya. Food Control 2019, 102, 173–178. [Google Scholar] [CrossRef]
- Ranjbar, R.; Dehkordi, F.S.; Shahreza, M.H.S.; Rahimi, E. Prevalence, identification of virulence factors, O-serogroups and antibiotic resistance properties of Shiga-toxin producing Escherichia coli strains isolated from raw milk and traditional dairy products. Antimicrob. Resist. Infect. Control 2018, 7, 1–11. [Google Scholar] [CrossRef] [PubMed]
- Madani, A.; Esfandiari, Z.; Shoaei, P.; Ataei, B. Evaluation of Virulence Factors, Antibiotic Resistance, and Biofilm Formation of Escherichia coli Isolated from Milk and Dairy Products in Isfahan, Iran. Foods 2022, 11, 960. [Google Scholar] [CrossRef] [PubMed]
- García-Anaya, M.C.; Sepulveda, D.R.; Sáenz-Mendoza, A.I.; Rios-Velasco, C.; Zamudio-Flores, P.B.; Acosta-Muñiz, C.H. Phages as biocontrol agents in dairy products. Trends Food Sci. Technol. 2020, 95, 10–20. [Google Scholar] [CrossRef]
- Ibekwe, A.M.; Lyon, S.R. Microbiological evaluation of fecal bacterial composition from surface water through aquifer sand material. J. Water Health 2008, 6, 411–421. [Google Scholar] [CrossRef] [PubMed]
- Bai, J.; Paddock, Z.D.; Shi, X.; Li, S.; An, B.; Nagaraja, T.G. Applicability of a multiplex PCR to detect the seven major Shiga toxin–producing Escherichia coli based on genes that code for serogroup-specific O-antigens and major virulence factors in cattle feces. Foodborne Pathog. Dis. 2012, 9, 541–548. [Google Scholar] [CrossRef] [PubMed]
- Bai, J.; Shi, X.; Nagaraja, T.G. A multiplex PCR procedure for the detection of six major virulence genes in Escherichia coli O157:H7. J. Microbiol. Methods 2010, 82, 85–89. [Google Scholar] [CrossRef] [PubMed]
- Nguyen, D.T.A.; Kanki, M.; Nguyen, P.D.; Le, H.T.; Ngo, P.T.; Tran, D.N.M.; Le, N.H.; Van Dang, C.; Kawai, T.; Kawahara, R.; et al. Prevalence, antibiotic resistance, and extended-spectrum and AmpC β-lactamase productivity of Salmonella isolates from raw meat and seafood samples in Ho Chi Minh City, Vietnam. Int. J. Food Microbiol. 2016, 236, 115–122. [Google Scholar] [CrossRef] [PubMed]
- Rebelo, A.R.; Bortolaia, V.; Kjeldgaard, J.S.; Pedersen, S.K.; Leekitcharoenphon, P.; Hansen, I.M.; Guerra, B.; Malorny, B.; Borowiak, M.; Hammerl, J.A.; et al. Multiplex PCR for detection of plasmid-mediated colistin resistance determinants, mcr-1, mcr-2, mcr-3, mcr-4 and mcr-5 for surveillance purposes. Eurosurveillance 2018, 23, 17-00672. [Google Scholar] [CrossRef] [PubMed]
- Borowiak, M.; Fischer, J.; Hammerl, J.A.; Hendriksen, R.S.; Szabo, I.; Malorny, B. Identification of a novel transposon-associated phosphoethanolamine transferase gene, mcr-5, conferring colistin resistance in d-tartrate fermenting Salmonella enterica subsp. enterica serovar Paratyphi B. J. Antimicrob. Chemother. 2017, 72, 3317–3324. [Google Scholar] [CrossRef]
- Duc, H.M.; Son, H.M.; Honjoh, K.; Miyamoto, T. Isolation and application of bacteriophages to reduce Salmonella contamination in raw chicken meat. LWT 2018, 91, 353–360. [Google Scholar] [CrossRef]
- Ibrahim, A.H.M.; Ali, M.E.E.; Ahmed, M.F.E.; Abdelkhalek, A. Prevalence and Characterization of Escherichia coli in Raw Milk and Some Dairy Products at Mansoura City. J. Adv. Vet. Res. 2022, 12, 363–370. [Google Scholar]
- Hussain, A.; Ali, S.; Shakir, H.A.; Qazi, J.I.; Ali, K.; Ullah, N. Prevalence of Escherichia coli in milk and different milk products sold under market conditions at Lahore. Sci. J. Anim. Sci. 2014, 3, 22–26. [Google Scholar]
- Bhoomika; Shakya, S.; Patyal, A.; Gade, N.E. Occurrence and characteristics of extended-spectrum β-lactamases producing Escherichia coli in foods of animal origin and human clinical samples in Chhattisgarh, India. Vet. World 2016, 9, 996–1000. [Google Scholar] [CrossRef]
- Islam, M.A.; Kabir, S.M.L.; Seel, S.K. Molecular detection and characterization of Escherichia coli isolated from raw milk sold in different markets of Bangladesh. Bangladesh J. Vet. Med. 2016, 14, 271–275. [Google Scholar] [CrossRef]
- Jayarao, B.M.; Henning, D.R. Prevalence of foodborne pathogens in bulk tank milk. J. Dairy Sci. 2001, 84, 2157–2162. [Google Scholar] [CrossRef] [PubMed]
- Awadallah, M.A.; Ahmed, H.A.; Merwad, A.M.; Selim, M.A. Occurrence, genotyping, shiga toxin genes and associated risk factors of E. coli isolated from dairy farms, handlers and milk consumers. Vet. J. 2016, 217, 83–88. [Google Scholar] [CrossRef]
- Ali, A.A.; Abdelgadir, W.S. Incidence of Escherichia coli in raw cow’s milk in Khartoum State. Br. J. Dairy Sci. 2011, 2, 23–26. [Google Scholar]
- Ombarak, R.A.; Hinenoya, A.; Awasthi, S.P.; Iguchi, A.; Shima, A.; Elbagory, A.-R.M.; Yamasaki, S. Prevalence and pathogenic potential of Escherichia coli isolates from raw milk and raw milk cheese in Egypt. Int. J. Food Microbiol. 2016, 221, 69–76. [Google Scholar] [CrossRef] [PubMed]
- World Health Organization. Control Measures for Shiga Toxin-Producing Escherichia coli (STEC) Associated with Meat and Dairy Products; World Health Organization: Geneva, Switzerland, 2022. [Google Scholar]
- Farrokh, C.; Jordan, K.; Auvray, F.; Glass, K.; Oppegaard, H.; Raynaud, S.; Thevenot, D.; Condron, R.; De Reu, K.; Govaris, A.; et al. Review of Shiga-toxin-producing Escherichia coli (STEC) and their significance in dairy production. Int. J. Food Microbiol. 2013, 162, 190–212. [Google Scholar] [CrossRef]
- Brown, C.A.; Harmon, B.G.; Zhao, T.; Doyle, M.P. Experimental Escherichia coli O157:H7 carriage in calves. Appl. Environ. Microbiol. 1997, 63, 27–32. [Google Scholar] [CrossRef]
- Chapman, P.A.; Malo, A.T.C.; Ellin, M.; Ashton, R.; Harkin, M.A. Escherichia coli O157 in cattle and sheep at slaughter, on beef and lamb carcasses and in raw beef and lamb products in South Yorkshire, UK. Int. J. Food Microbiol. 2001, 64, 139–150. [Google Scholar] [CrossRef] [PubMed]
- Bagel, A.; Sergentet, D. Shiga Toxin-Producing Escherichia coli and Milk Fat Globules. Microorganisms 2022, 10, 496. [Google Scholar] [CrossRef]
- Ruegg, P.L. Practical food safety interventions for dairy production. J. Dairy Sci. 2003, 86, E1–E9. [Google Scholar] [CrossRef]
- Alharbi, M.G.; Al-Hindi, R.R.; Esmael, A.; Alotibi, I.A.; Azhari, S.A.; Alseghayer, M.S.; Teklemariam, A.D. The ‘Big Six’: Hidden Emerging Foodborne Bacterial Pathogens. Trop. Med. Infect. Dis. 2022, 7, 356. [Google Scholar] [CrossRef] [PubMed]
- Friedrich, A.W.; Bielaszewska, M.; Zhang, W.-L.; Pulz, M.; Kuczius, T.; Ammon, A.; Karch, H. Escherichia coli Harboring Shiga Toxin 2 Gene Variants: Frequency and Association with Clinical Symptoms. J. Infect. Dis. 2002, 185, 74–84. [Google Scholar] [CrossRef] [PubMed]
- Hua, Y.; Zhang, J.; Jernberg, C.; Chromek, M.; Hansson, S.; Frykman, A.; Xiong, Y.; Wan, C.; Matussek, A.; Bai, X. Molecular Characterization of the Enterohemolysin Gene (ehxA) in Clinical Shiga Toxin-Producing Escherichia coli Isolates. Toxins 2021, 13, 71. [Google Scholar] [CrossRef] [PubMed]
- Cobbold, R.N.; Davis, M.A.; Rice, D.H.; Szymanski, M.; Tarr, P.I.; Besser, T.E.; Hancock, D.D. Associations between bovine, human, and raw milk, and beef isolates of non-O157 Shiga toxigenic Escherichia coli within a restricted geographic area of the United States. J. Food Prot. 2008, 71, 1023–1027. [Google Scholar] [CrossRef] [PubMed]
- Lynch, M.J.; Fox, E.M.; O’Connor, L.; Jordan, K.; Murphy, M. Surveillance of Verocytotoxigenic Escherichia coli in Irish Bovine Dairy Herds. Zoonoses Public Health 2012, 59, 264–271. [Google Scholar] [CrossRef] [PubMed]
- Claeys, W.L.; Cardoen, S.; Daube, G.; De Block, J.; Dewettinck, K.; Dierick, K.; De Zutter, L.; Huyghebaert, A.; Imberechts, H.; Thiange, P.; et al. Raw or heated cow milk consumption: Review of risks and benefits. Food Control 2012, 31, 251–262. [Google Scholar] [CrossRef]
- Fallah, N.; Ghaemi, M.; Ghazvini, K.; Rad, M.; Jamshidi, A. Occurrence, pathotypes, and antimicrobial resistance profiles of diarrheagenic Escherichia coli strains in animal source food products from public markets in Mashhad, Iran. Food Control 2021, 121, 107640. [Google Scholar] [CrossRef]
- Elafify, M.; Khalifa, H.O.; Al-Ashmawy, M.; Elsherbini, M.; El Latif, A.A.; Okanda, T.; Matsumoto, T.; Koseki, S.; Abdelkhalek, A. Prevalence and antimicrobial resistance of Shiga toxin-producing Escherichia coli in milk and dairy products in Egypt. J. Environ. Sci. Health B 2020, 55, 265–272. [Google Scholar] [CrossRef]
- EFSA. Technical specifications for the monitoring and reporting of verotoxigenic Escherichia coli (VTEC) on animals and food (VTEC surveys on animals and food). EFSA J. 2009, 7, 1366. [Google Scholar] [CrossRef]
- Pradel, N.; Bertin, Y.; Martin, C.; Livrelli, V. Molecular analysis of Shiga toxin-producing Escherichia coli strains isolated from hemolytic-uremic syndrome patients and dairy samples in France. Appl. Environ. Microbiol. 2008, 74, 2118–2128. [Google Scholar] [CrossRef]
- Vu, T.V.D.; Do, T.T.N.; Rydell, U.; Nilsson, L.E.; Olson, L.; Larsson, M.; Hanberger, H.; Choisy, M.; Dao, T.T.; van Doorn, H.R.; et al. Antimicrobial susceptibility testing and antibiotic consumption results from 16 hospitals in Viet Nam: The VINARES project 2012–2013. J. Glob. Antimicrob. Resist. 2019, 18, 269–278. [Google Scholar] [CrossRef]
- Torumkuney, D.; Kundu, S.; Van Vu, G.; Nguyen, H.A.; Van Pham, H.; Kamble, P.; Lan, N.T.H.; Keles, N. Country data on AMR in Vietnam in the context of community-acquired respiratory tract infections: Links between antibiotic susceptibility, local and international antibiotic prescribing guidelines, access to medicines and clinical outcome. J. Antimicrob. Chemother. 2022, 77, i26–i34. [Google Scholar] [CrossRef] [PubMed]
- Oliver, S.P.; Murinda, S.E.; Jayarao, B.M. Impact of antibiotic use in adult dairy cows on antimicrobial resistance of veterinary and human pathogens: A comprehensive review. Foodborne Pathog. Dis. 2011, 8, 337–355. [Google Scholar] [CrossRef] [PubMed]
- Virto, M.; Santamarina-García, G.; Amores, G.; Hernández, I. Antibiotics in Dairy Production: Where Is the Problem? Dairy 2022, 3, 541–564. [Google Scholar] [CrossRef]
- Zanella, G.N.; Mikcha, J.M.G.; Bando, E.; Siqueira, V.L.D.; MacHinski, M. Occurrence and antibiotic resistance of coliform bacteria and antimicrobial residues in pasteurized cow’s milk from Brazil. J. Food Prot. 2010, 73, 1684–1687. [Google Scholar] [CrossRef] [PubMed]
- Landers, T.F.; Cohen, B.; Wittum, T.E.; Larson, E.L. A Review of Antibiotic Use in Food Animals: Perspective, Policy, and Potential. Public Health Rep. 2012, 127, 4–22. [Google Scholar] [CrossRef]
- Falgenhauer, L.; Imirzalioglu, C.; Oppong, K.; Akenten, C.W.; Hogan, B.; Krumkamp, R.; Poppert, S.; Levermann, V.; Schwengers, O.; Sarpong, N.; et al. Detection and characterization of ESBL-producing Escherichia coli from humans and poultry in Ghana. Front. Microbiol. 2019, 9, 3358. [Google Scholar] [CrossRef]
- Danaei, B.; Sarmastzadeh, T.; Khalili, F.; Yazarlou, F.; Centis, R.; D'Ambrosio, L.; Sotgiu, G.; Migliori, G.B.; Nasiri, M.J. The battle against colistin-resistant E. coli and the need for a one health approach. New Microbes New Infect. 2023, 54, 101161. [Google Scholar] [CrossRef] [PubMed]
- Filioussis, G.; Kachrimanidou, M.; Christodoulopoulos, G.; Kyritsi, M.; Hadjichristodoulou, C.; Adamopoulou, M.; Tzivara, A.; Kritas, S.K.; Grinberg, A. Short communication: Bovine mastitis caused by a multidrug-resistant, mcr-1-positive (colistin-resistant), extended-spectrum β-lactamase–producing Escherichia coli clone on a Greek dairy farm. J. Dairy Sci. 2020, 103, 852–857. [Google Scholar] [CrossRef] [PubMed]
- Haenni, M.; Poirel, L.; Kieffer, N.; Châtre, P.; Saras, E.; Métayer, V.; Dumoulin, R.; Nordmann, P.; Madec, J.-Y. Co-occurrence of extended spectrum β lactamase and MCR-1 encoding genes on plasmids. Lancet Infect. Dis. 2016, 16, 281–282. [Google Scholar] [CrossRef] [PubMed]
- Gutiérrez, D.; Fernández, L.; Rodríguez, A.; García, P. Role of Bacteriophages in the Implementation of a Sustainable Dairy Chain. Front. Microbiol. 2019, 10, 12. [Google Scholar] [CrossRef] [PubMed]
- Strauch, E.; Hammerl, J.A.; Hertwig, S. Bacteriophages: New Tools for Safer Food? J. Verbraucherschutz Leb. 2007, 2, 138–143. [Google Scholar] [CrossRef]
- Klumpp, J.; Loessner, M.J. New research on bacteriophages and food safety. In Advances in Microbial Food Safety; Elsevier: Amsterdam, The Netherlands, 2013; pp. 321–339. [Google Scholar] [CrossRef]
- Mahony, J.; McAuliffe, O.; Ross, R.P.; van Sinderen, D. Bacteriophages as biocontrol agents of food pathogens. Food Biotechnol.–Plant Biotechnol. 2011, 22, 157–163. [Google Scholar] [CrossRef]
- Sabour, P.M.; Griffiths, M.W. (Eds.) Bacteriophages in the Control of Food- and Waterborne Pathogens; American Society of Microbiology: Washington, DC, USA, 2010. [Google Scholar] [CrossRef]
- McLean, S.K.; Dunn, L.A.; Palombo, E.A. Phage inhibition of Escherichia coli in ultrahigh-temperature-treated and raw milk. Foodborne Pathog. Dis. 2013, 10, 956–962. [Google Scholar] [CrossRef] [PubMed]
- Grygorcewicz, B.; Chajęcka-Wierzchowska, W.; Augustyniak, A.; Wasak, A.; Stachurska, X.; Nawrotek, P.; Dołęgowska, B. In-milk inactivation of Escherichia coli O157:H7 by the environmental lytic bacteriophage ECPS-6. J. Food Saf. 2020, 40, e12747. [Google Scholar] [CrossRef]
- Duc, H.M.; Zhang, Y.; Hoang, S.M.; Masuda, Y.; Honjoh, K.-I.; Miyamoto, T. The Use of Phage Cocktail and Various Antibacterial Agents in Combination to Prevent the Emergence of Phage Resistance. Antibiotics 2023, 12, 1077. [Google Scholar] [CrossRef]
- Furuta, M.; Nasu, T.; Umeki, K.; Hoang, D.M.; Honjoh, K.-I.; Miyamoto, T. Characterization and Application of Lytic Bacteriophages against Campylobacter jejuni Isolated from Poultry in Japan. Biocontrol. Sci. 2017, 22, 213–221. [Google Scholar] [CrossRef]

| Target Gene | Primer | Primer Sequence (5′–3′) | Amplicon Size (bp) | References |
|---|---|---|---|---|
| wzxO45 | O45-F | GGGGCTGTCCAGACAGTTCAT | 890 | [35] |
| O45-F | TGTACTGCACCCAATGCACCT | |||
| wzxO103 | O103-F | GCAGAAAATCAAGGTGATTACG | 740 | |
| O103-R | GGTTAAAGCCATGCTCAACG | |||
| stx1 | stx1-F | TGTCGCATAGTGGAACCTCA | 655 | [36] |
| stx1-R | TGCGCACTGAGAAGAAGAGA | |||
| wzqEO121-wzqFO121 | O121-F | TCAGCAGAGTGGAACTAATTTTGT | 587 | [35] |
| O121-R | TGAGCACTAGATGAAAAGTATGGCT | |||
| wzxO145 | O145-F | TCAAGTGTTGGATTAAGAGGGATT | 523 | |
| O145-R | CACTCGCGGACACAGTACC | |||
| stx2 | stx2-F | CCATGACAACGGACAGCAGTT | 477 | [36] |
| stx2-R | TGTCGCCAGTTATCTGACATTC | |||
| wzxO26 | O26-F | AGGGTGCGAATGCCATATT | 417 | [35] |
| O26-R | GACATAATGACATACCACGAGCA | |||
| eae | eae-F | CATTATGGAACGGCAGAGGT | 375 | [36] |
| eae-R | ACGGATATCGAAGCCATTTG | |||
| rfbO157 | O157-F | CAGGTGAAGGTGGAATGGTTGTC | 296 | [35] |
| O157-F | TTAGAATTGAGACCATCCAATAAG | |||
| wzxO111 | O111-F | TGCATCTTCATTATCACACCA | 230 | [35] |
| O111-R | ACCGCAAATGCGATAATAACA | |||
| ehxA | ehxA-F | GCGAGCTAAGCAGCTTGAAT | 199 | [36] |
| ehxA-R | CTGGAGGCTGCACTAACTCC |
| Target Gene | Primer | Primer Sequence (5′–3′) | Amplicon Size (bp) |
|---|---|---|---|
| blaTEM | TEM-F | GGTCGCCGCATACACTATTCTC | 372 |
| TEM-R | TTTTATCCGCCTCCATCCAGTC | ||
| blaSHV | SHV-F | CCAGCAGGATCTGGTGGACTAC | 231 |
| SHV-R | CCGGGAAGCGCCCTCCAT | ||
| blaCTX-M-1 | CTX-M1-F | GAATTAGAGCGGGAGTCGGG | 588 |
| CTX-M1-R | CACAACCCAGGAAGCAGGC | ||
| blaCTX-M-2 | CTX-M2-F | GATGGCGACGCTACCCC | 107 |
| CTX-M2-R | CAAGCCGACCTCCCGAAC | ||
| blaCTX-M-9 | CTX-M9-F | GTGCAACGGATGATGTTCGC | 475 |
| CTX-M9-R | GAAACGTCTCATCGCCGATC | ||
| blaCTX-M-8/25 | CTX-M8/25-F | GCGACCCGCGCGATAC | 186 |
| CTX-M8/25-R | TGCCGGTTTTATCCCCG |
| Target Gene | Primer | Primer Sequence (5′–3′) | Amplicon Size (bp) | Reference |
|---|---|---|---|---|
| mcr-1 | mcr1 f | AGTCCGTTTGTTCTTGTGGC | 320 | [38] |
| mcr1 r | AGATCCTTGGTCTCGGCTTG | |||
| mcr-2 | mcr2 f | CAAGTGTGTTGGTCGCAGTT | 715 | [38] |
| mcr2 r | TCTAGCCCGACAAGCATACC | |||
| mcr-3 | mcr 3 f | AAATAAAAATTGTTCCGCTTATG | 929 | [38] |
| mcr3 r | AATGGAGATCCCCGTTTTT | |||
| mcr-4 | mcr4 f | TCACTTTCATCACTGCGTTG | 1116 | [38] |
| mcr4 r | TTGGTCCATGACTACCAATG | |||
| mcr-5 | mcr5 f | ATGCGGTTGTCTGCATTTATC | 1644 | [39] |
| mcr 5 r | TCATTGTGGTTGTCCTTTTCTG |
| Group | Name of Antibiotic | MIC Breakpoint (µg/mL) | Number (%) of Resistant Strains | Total (n = 139) | |
|---|---|---|---|---|---|
| Ba Vi (n = 61) | Gia Lam (n = 78) | ||||
| Penicillin | ampicillin | 32 | 22 (36.07) | 16 (20.51) | 38 (27.34) |
| Cephalosporins | cefotaxime | 4 | 5 (8.2) | 2 (2.56) | 7 (5.04) |
| ceftazidime | 16 | 2 (3.28) | 1 (1.28) | 3 (2.16) | |
| cefoxitin | 32 | 1 (1.64) | 3 (3.85) | 4 (2.88) | |
| cefepime | 16 | 5 (8.2) | 2 (2.56) | 7 (5.04) | |
| Carbapenems | meropenem | 4 | 0 | 0 | 0 |
| Polymyxins | colistin | 4 | 2 (3.28) | 2 (2.56) | 4 (2.88) |
| Tetracyclines | tetracycline | 16 | 21 (34.43) | 11 (14.1) | 32 (23.02) |
| Aminoglycosides | streptomycin | 32 | 22 (36.07) | 13 (16.67) | 35 (25.18) |
| gentamicin | 16 | 2 (3.28) | 1 (1.28) | 3 (2.16) | |
| Macrolides | azithromycin | 32 | 13 (21.31) | 0 | 13 (9.35) |
| Phenicols | florfenicol | 16 | 6 (9.84) | 5 (6.41) | 11 (7.91) |
| Sulfonamide | co-trime | 4/76 | 27 (44.26) | 11 (14.1) | 38 (27.34) |
| Fluoroquinolones | ciprofloxacin | 4 | 2 (3.28) | 1 (1.28) | 3 (2.16) |
| Quinolones | nalidixic acid | 32 | 3 (4.92) | 2 (2.56) | 5 (3.6) |
| No. of Antibiotics | Resistance Phenotype | Number (%) of Resistance Isolates | ||
|---|---|---|---|---|
| Ba Vi (n = 61) | Gia lam (n = 78) | Total (n = 139) | ||
| 0 | - | 21 (34.43) | 61 (78.21) | 82 (58.99) |
| 1 | SXT | 4 (6.65) | 0 | 4 (2.88) |
| FLO | 2 (3.28 | 0 | 2 (1.44) | |
| AMP | 1 (1.64) | 0 | 1 (0.72) | |
| CST | 0 | 1 (1.28) | 1 (0.72) | |
| 2 | AZM-SXT | 6 (9.84) | 0 | 6 (4.320 |
| AMP-STR | 3 (4.92) | 0 | 3 (2.16) | |
| AMP-FOX | 0 | 2 (2.56) | 2 (1.44) | |
| TET-SXT | 2 (3.28) | 0 | 2 (1.44) | |
| STR-SXT | 1 (1.64) | 0 | 1 (0.72) | |
| 3 | AMP-FOX-STR | 0 | 1 (1.28) | 1 (0.72) |
| AMP-STR-CST | 1 (1.64) | 0 | 1 (0.72) | |
| AMP-STR-TET | 1 (1.64) | 0 | 1 (0.72) | |
| TET-AZM-SXT | 1 (1.64) | 0 | 1 (0.72) | |
| 4 | AMP-STR-TET-SXT | 4 (6.65) | 5 (6.41) | 9 (6.47) |
| AMP-STR-FLO-SXT | 0 | 1 (1.28) | 1 (0.72) | |
| STR-TET-CST-SXT | 1 (1.64) | 0 | 1 (0.72) | |
| 5 | AMP-STR-TET-FLO-SXT | 2 (3.28) | 4 (5.13) | 6 (4.32) |
| AMP-STR-TET-AZM-SXT | 4 (6.65) | 0 | 4 (2.88) | |
| AMP-CTX-FEP-STR-TET | 1 (1.64) | 0 | 1 (0.72) | |
| AMP-GEN-STR-TET-SXT | 0 | 1 (1.28) | 1 (0.72) | |
| FOX-STR-TET-AZM-SXT | 1 (1.64) | 0 | 1 (0.72) | |
| 6 | AMP-CTX-FEP-CAZ-CIP-NAL | 1 (1.64) | 1 (1.28) | 2 (1.44) |
| AMP-CTX-FEP-GEN-TET-SXT | 1 (1.64) | 0 | 1 (0.72) | |
| AMP-GEN-STR-TET-FLO-AZM | 1 (1.64) | 0 | 1 (0.72) | |
| 7 | AMP-CTX-FEP-STR-TET-CIP-NAL | 1 (1.64) | 0 | 1 (0.72) |
| AMP-CTX-FEP-STR-TET-CST-NAL | 0 | 1 (1.28) | 1 (0.72) | |
| 8 | AMP-CTX-FEP-CAZ-STR-TET-FLO-NAL | 1 (1.64) | 0 | 1 (0.72) |
| Resistant ≥ 1 | 40 (65.57) | 17 (21.79) | 57 (41.01) | |
| MDR | 21 (34.43) | 14 (17.95) | 35 (25.18) | |
| Isolate ID | Antimicrobial Resistance Profile | ESBL Screening Test | β-Lactamase Encoding Genes | mcr Genes |
|---|---|---|---|---|
| EM2 | AMP-CTX-FEP-GEN-TET-SXT | + | blaTEM, blaCTX-M-1 | ND |
| EM29 | AMP-CTX-FEP-CAZ-CIP-NAL | + | blaTEM | ND |
| EM32 | STR-TET-CST-SXT | ND | ND | mcr-1 |
| EM40 | AMP-STR-CST | ND | ND | mcr-1 |
| EM42 | AMP-CTX-FEP-STR-TET-CIP-NAL | + | blaTEM, blaCTX-M-1 | ND |
| EM72 | AMP-CTX-FEP-CAZ-STR-TET-FLO-NAL | + | blaTEM, blaCTX-M-1 | ND |
| EM75 | AMP-CTX-FEP-STR-TET | + | blaCTX-M-1 | ND |
| EM102 | AMP-CTX-FEP-CAZ-CIP-NAL | + | blaTEM | ND |
| EM144 | CST | ND | ND | mcr-1 |
| EM148 | AMP-CTX-FEP-STR-TET-CST-NAL | + | blaTEM, blaCTX-M-1 | mcr-1 |
Disclaimer/Publisher’s Note: The statements, opinions and data contained in all publications are solely those of the individual author(s) and contributor(s) and not of MDPI and/or the editor(s). MDPI and/or the editor(s) disclaim responsibility for any injury to people or property resulting from any ideas, methods, instructions or products referred to in the content. |
© 2024 by the authors. Licensee MDPI, Basel, Switzerland. This article is an open access article distributed under the terms and conditions of the Creative Commons Attribution (CC BY) license (https://creativecommons.org/licenses/by/4.0/).
Share and Cite
Duc, H.M.; Hoa, T.T.K.; Ha, C.T.T.; Hung, L.V.; Thang, N.V.; Son, H.M.; Flory, G.A. Antibiotic Resistance Profile and Bio-Control of Multidrug-Resistant Escherichia coli Isolated from Raw Milk in Vietnam Using Bacteriophages. Pathogens 2024, 13, 494. https://doi.org/10.3390/pathogens13060494
Duc HM, Hoa TTK, Ha CTT, Hung LV, Thang NV, Son HM, Flory GA. Antibiotic Resistance Profile and Bio-Control of Multidrug-Resistant Escherichia coli Isolated from Raw Milk in Vietnam Using Bacteriophages. Pathogens. 2024; 13(6):494. https://doi.org/10.3390/pathogens13060494
Chicago/Turabian StyleDuc, Hoang Minh, Tran Thi Khanh Hoa, Cam Thi Thu Ha, Le Van Hung, Nguyen Van Thang, Hoang Minh Son, and Gary A. Flory. 2024. "Antibiotic Resistance Profile and Bio-Control of Multidrug-Resistant Escherichia coli Isolated from Raw Milk in Vietnam Using Bacteriophages" Pathogens 13, no. 6: 494. https://doi.org/10.3390/pathogens13060494
APA StyleDuc, H. M., Hoa, T. T. K., Ha, C. T. T., Hung, L. V., Thang, N. V., Son, H. M., & Flory, G. A. (2024). Antibiotic Resistance Profile and Bio-Control of Multidrug-Resistant Escherichia coli Isolated from Raw Milk in Vietnam Using Bacteriophages. Pathogens, 13(6), 494. https://doi.org/10.3390/pathogens13060494
